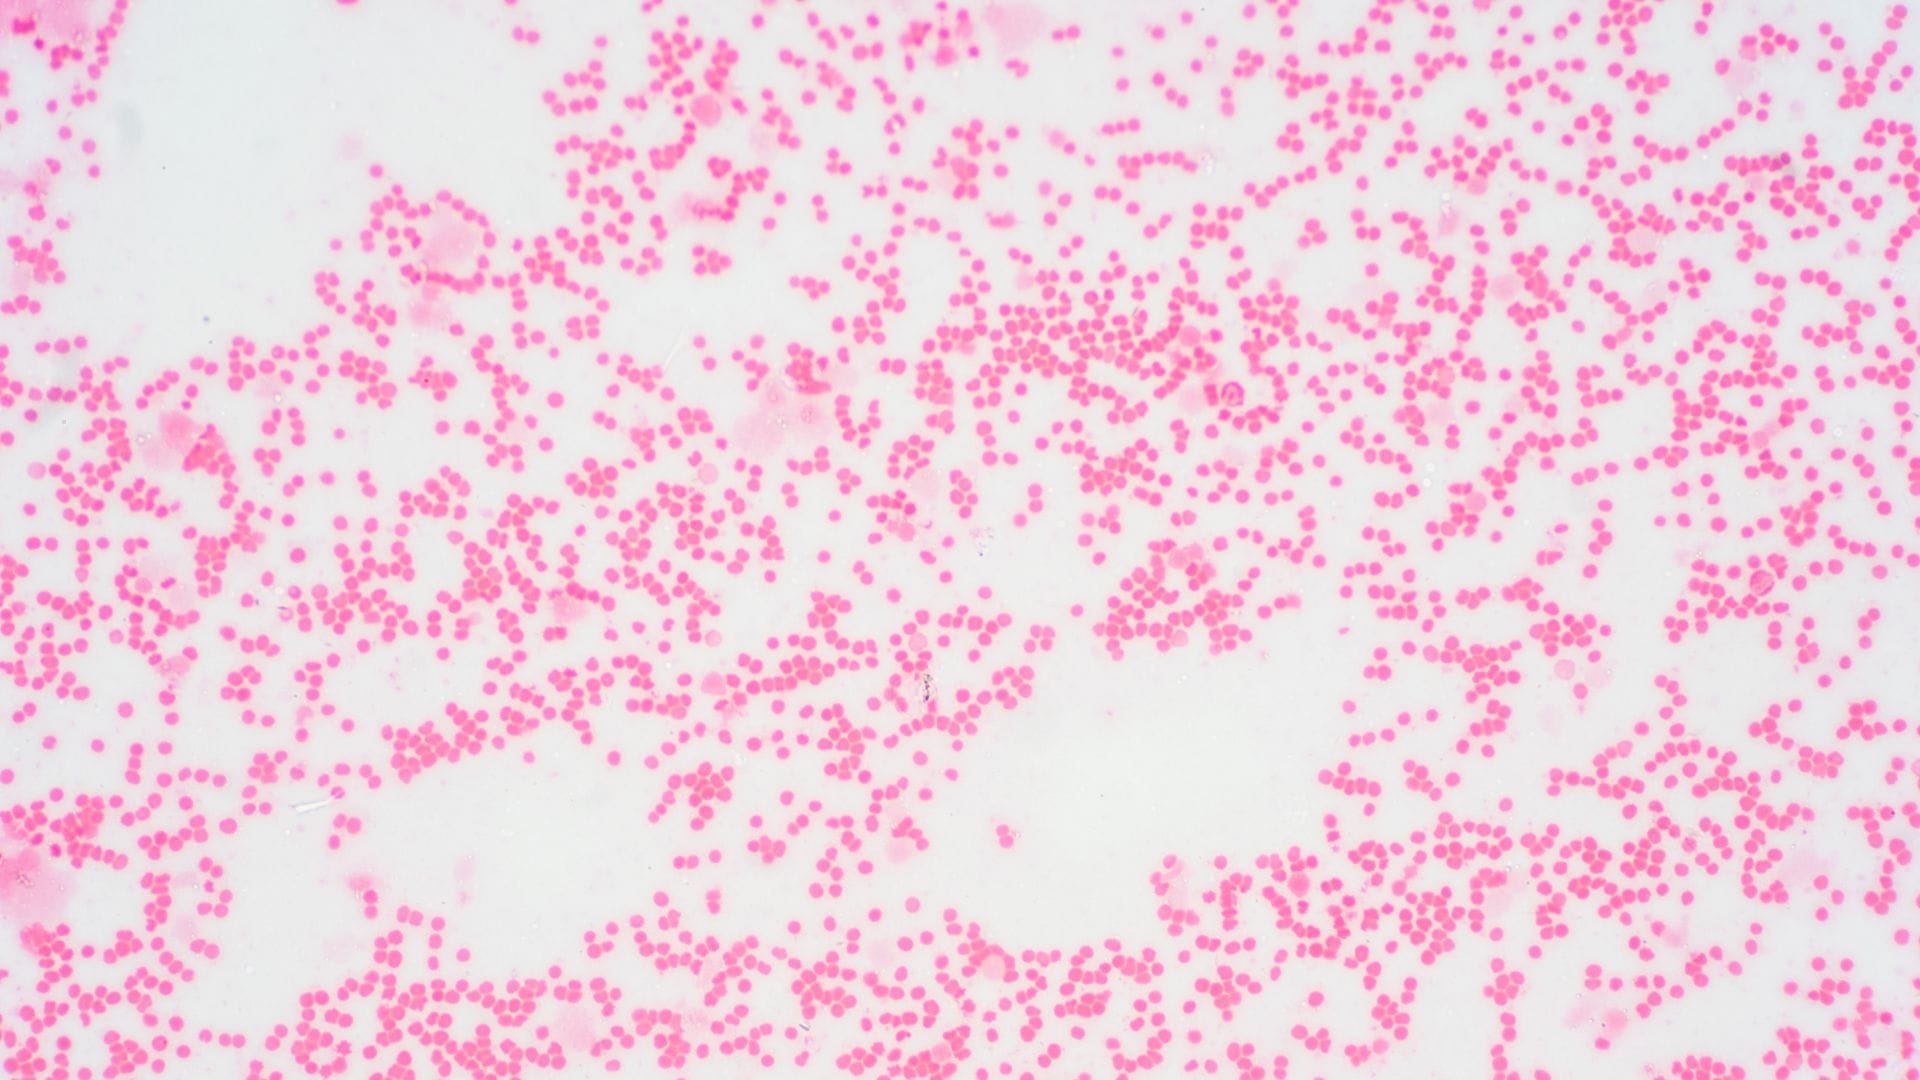

Los síndromes mielodisplásicos son un tipo de enfermedad poco frecuente – 3,29 casos cada 1000.000 habitantes- que surge como consecuencia de “una médula ósea que trabaja poco y mal”, en palabras Ana Alfonso, hematóloga de la Clínica Universitaria de Navarra. Descubrimos lo básico de este cáncer que afecta especialmente a la población de mayor edad.
¿Qué es el síndrome mielodisplásico?
Es un grupo de enfermedades tumorales que afectan a la célula madre de la médula ósea, provocando que las células de la sangre se formen de manera defectuosa (displasia) y además que se mueran demasiado pronto.
¿Y esto en qué se traduce?
En pacientes con niveles bajos de células sanguíneas sanas. Por tanto, personas con anemia (se da en el 80 % de los casos), leucopenia o trombopenia. La falta de hematíes sanos hará que acumulen fatiga y cansancio. En el caso de les falten plaquetas, tendrán mayor propensión a los sangrados. Y la escasez de leucocitos les producirá mayor riesgo a contraer infecciones.
¿Existen factores de riesgo?
Sí. Primero hay que apuntar el tema de la edad- la media de los pacientes es de 75 años- y después hay un factor de riesgo destacado como haber pasado otro cáncer y haber recibido quimio y radioterapia previa, como explica la hematóloga Ana Alfonso. También hay que considerar la exposición a tóxicos y el tabaquismo, aunque el impacto de este último es mucho menor que en otras neoplasias como el cáncer de pulmón.
Con el diagnóstico en la mano, ¿Cuál es el pronóstico?
Variable. En función de la mayor o menor probabilidad de que la enfermedad se transforme en una leucemia aguda- algo que determinará el imprescindible estudio molecular de las mutaciones- se establecen dos grupos. En pacientes de riesgo bajo, con una supervivencia similar a la de la población general, el objetivo será mejorar la calidad de vida. Mientras, en los de riesgo alto, se buscará mejorar la supervivencia (pude ser de meses). Los síndromes mielodisplásicos son enfermedades de por vida, y la única manera de curar a estos pacientes es hacerle un trasplante de un paciente sano.
Y finalmente, cuál es el tratamiento
En los casos de bajo riesgo, si no hay síntomas, se hará una vigilancia activa. Se recurrirá a los estimulantes de la médula ósea para mejorar la anemia, la leucopenia o la trombopenia que puedan presentar. Y si la anemia persiste, a las transfusiones de sangre y tratamientos dirigidos.
En el caso de pacientes de alto riesgo, la solución idónea sería el trasplante de médula de un donante sano, si bien por la edad, la mayoría no pueden ser candidatos al trasplante. Si no es posible, hay que “educar la enfermedad” y, cuando sea posible, recurrir a ensayos clínicos con nuevos fármacos.